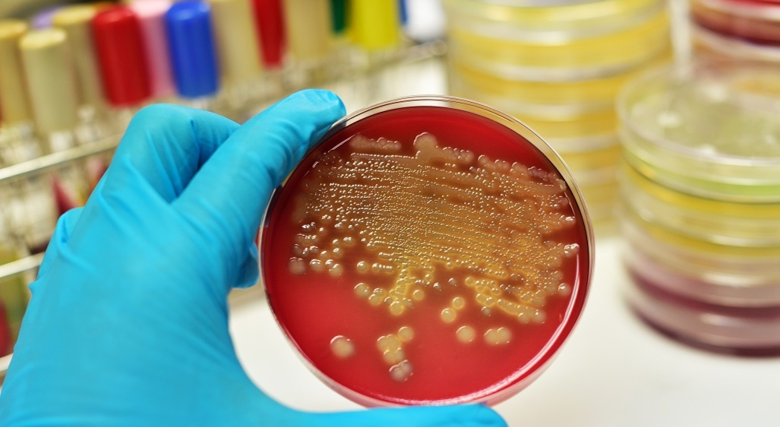
زراعة البراز: ثورة ميكروبية في عالم علاج السرطان

زراعة البراز: ثورة ميكروبية في عالم علاج السرطان
زراعة البراز: ثورة ميكروبية في عالم علاج السرطان
بقلم: إيهاب محمد زايد
في عالم يبحث عن حلول مبتكرة لمعركة السرطان التي تودي بحياة عشرة ملايين شخص سنوياً عالمياً، وبينما تنفق الدول المليارات على العقاقير الكيميائية والعلاجات الإشعاعية، تطل علينا من حيث لا نتوقع ثورة علاجية تحمل في طياتها مفارقة صادمة: علاج السرطان قد يكون مختبئاً في أمعائنا، بل وفي محتوياتها الأقل جمالية. هذا ليس خيالاً علمياً، بل هو واقع طبي دعمته دراسة نشرت في مجلة “نيتشر ميديسين” المرموقة في يناير 2026، تفتح نافذة أمل جديدة لمرضى سرطان الكلى وسرطان الرئة غير صغير الخلايا.
المفارقة المصرية: بين ثقافة الحياء والعلاجات الثورية
في مجتمع مصري يحافظ على حياء عميق تجاه الأمور الجسدية الخاصة، قد تبدو فكرة “زراعة البراز” أو نقل الميكروبيوم البرازي صادمة للكثيرين. لكن الأرقام المرعبة التي تشير إلى إصابة مائة ألف مصري جديد بالسرطان سنوياً (وفقاً لتقرير السجل القومي للأورام 2024)، ووفاة خمسين ألفاً منهم، تجعلنا نعيد التفكير في كل الاحتمالات. ماذا لو كان جزء من الحل يكمن في نظامنا البيئي الداخلي، في تلك البكتيريا التي تتعايش معنا منذ الولادة؟
التجربة التاريخية: من سرطان الجلد إلى سرطان الكلى
الدراسة التي قادها الباحث الإيطالي جيانلوكا إيانيو من الجامعة الكاثوليكية للقلب المقدس في روما، تمثل نقلة نوعية في تاريخ الأبحاث. فبينما ركزت الدراسات السابقة على سرطان الجلد (الميلانوما)، جاءت هذه الدراسة لتتناول سرطان الكلى – الذي يمثل 2-3% من كل السرطانات في مصر حسب إحصاءات المعهد القومي للأورام. شملت الدراسة خمسة وأربعين مريضاً بدأوا العلاج بمثبطات نقاط التفتح المناعية (بيمبروليزوماب) بالإضافة إلى عقار أكسيتينيب الذي يقطع الإمداد الدموي عن الأورام.
النتائج المذهلة: ضعف فترة الاستقرار ونصف المرضى يستجيبون
التصميم الدقيق للدراسة أعطى مصداقية غير مسبوقة للنتائج. تم تقسيم المرضى عشوائياً إلى مجموعتين: مجموعة تلقت زراعة براز من متبرع شفي تماماً من السرطان بعد العلاج المناعي، ومجموعة تلقت محلولاً ملحياً وهمياً. النتائج بعد متابعة دقيقة كانت مذهلة:
في مجموعة زراعة البراز، ظل السرطان مستقراً لمدة عامين في المتوسط، مقارنة بتسعة أشهر فقط في المجموعة الوهمية. ولكن الأكثر إثارة هو أن 51.2% من المرضى في مجموعة الزراعة شهدوا انكماشاً في حجم الأورام، مقابل 34.8% فقط في المجموعة الوهمية. هذه النسبة تمثل زيادة بنسبة 47% في فعالية العلاج.
سر البكتيريا النافعة: من “بلوتيا ويكسليراي” إلى أحماض دهنية قصيرة السلسلة
السؤال الذي يطرح نفسه: كيف تمكنت بكتيريا من أمعاء شخص ما من محاربة السرطان في شخص آخر؟ التحاليل المخبرية كشفت سراً مدهشاً. زراعة البراز أدخلت نوعاً محدداً من البكتيريا يسمى “بلوتيا ويكسليراي” – بكتيريا منتجة لأحماض دهنية قصيرة السلسلة معروفة بتعزيز الخلايا المناعية المضادة للسرطان.
ولم يتوقف الأمر عند هذا الحد، فقد أدت الزراعة أيضاً إلى تغييرات عميقة في النظام البيئي البكتيري القائم. انخفضت مستويات سلالة معينة من بكتيريا “إيشيريشيا كولاي” التي تسبب التهابات ضارة، بينما ارتفعت مستويات بكتيريا “رومينوكوكس بروميي” التي تشجع نمو بكتيريا أخرى منتجة للأحماض الدهنية المفيدة.
الآلية العلمية: الميكروبيوم كمنظم رئيسي للمناعة
يكمن السر في العلاقة المعقدة بين الميكروبيوم المعوي والجهاز المناعي. البروفيسور هاسان زارور من جامعة بيتسبيرج يشرح: “الميكروبيوم منظم قوي للمناعة المضيفة، لذا افترضنا أن تغييره يمكن أن يعزز المناعة للمساعدة في قتل السرطان”. في مصر، حيث يعاني 30% من مرضى السرطان من ضعف في الاستجابة للعلاجات المناعية حسب دراسة في المعهد القومي للأورام، قد تكون زراعة البراز حلاً ثورياً.
دراسة موازية: نجاح مذهل مع سرطان الرئة
ولتأكيد هذه النتائج، صدرت في الأسبوع نفسه دراسة أخرى صغيرة أظهرت أن زراعة البراز يمكن أن تعزز بشكل كبير آثار مثبطات نقاط التفتح المناعية لدى مرضى سرطان الرئة غير صغير الخلايا، مقارنة بأولئك الذين يتلقون العلاج المناعي وحده. الباحثة أرييل إلكريف من جامعة مونتريال في كندا، والتي شاركت في دراسة سرطان الرئة، تؤكد أن هذه النتائج تشير إلى إمكانية عمل زراعة البراز ضد أنواع أورام أخرى تستجيب لمثبطات نقاط التفتح – مثل تلك التي تصيب المثانة والرأس والعنق.
التحديات الأخلاقية والعلمية: طريق طويل نحو العلاج المعياري
رغم هذه النتائج الواعدة، يبقى الطريق طويلاً أمام اعتماد هذا العلاج على نطاق واسع. الباحث إيانيو يشير إلى ضرورة تحديد السلالات البكتيرية المفيدة بدقة داخل البراز، مما يمكن من إنشاء عينات ميكروبية اصطناعية يمكن إنتاجها لعلاج السرطان على نطاق واسع.
في السياق المصري، تواجه هذه التقنية تحديات إضافية. الدكتور أحمد مصطفى، أستاذ الأورام في جامعة القاهرة، يوضح: “نحتاج إلى بنوك براز مصرية، متبرعين مصريين، ومعايير مصرية تلائم الميكروبيوم المصري الذي يختلف عن نظيره الغربي بسبب الاختلافات الغذائية والبيئية والوراثية”.
الفوائد المتوقعة: من العلاج الفردي إلى الطب الدقيق
الأمل الأكبر يكمن في تحويل هذه التقنية إلى “طب دقيق ميكروبي”. بدلاً من زراعة براز كامل، يمكن تحديد مزيج بكتيري محدد لكل نوع سرطان، بل وربما لكل مريض حسب تركيبة ميكروبيومه الفريدة. هذا قد يخفض تكلفة العلاج ويقلل المخاطر المحتملة للعدوى.
الخاتمة: من القرف إلى الأمل
في النهاية، نحن أمام تحول جذري في مفهومنا للعلاج والشفاء. البراز، الذي ظللنا ننظر إليه كمخلفات يجب التخلص منها، يتحول إلى كنز علاجي محتمل. في مصر، حيث تموت امرأة كل ساعة بسبب سرطان الثدي، ويموت رجل كل خمس ساعات بسبب سرطان الكبد (حسب إحصاءات 2024)، يجب أن نكون منفتحين على كل الاحتمالات العلاجية.
الثورة الميكروبية في علاج السرطان تذكرنا بحقيقة عميقة: أجسادنا ليست مجرد مجموعات من الخلايا البشرية، بل هي أنظمة بيئية كاملة، تعيش فيها تريليونات الكائنات الدقيقة التي تؤثر في صحتنا أكثر مما نتخيل. ربما حان الوقت لأن نغير نظرتنا، من اعتبار هذه الكائنات “ضيوفاً غير مرغوب فيهم” إلى اعتبارها “شركاء في الصحة والحياة”.
العلاج المستقبلي للسرطان قد لا يأتي من مختبرات الأدوية الفاخرة فقط، بل من فهم أعمق لتوازننا الداخلي، من احترام النظام البيئي الذي نحمله في أحشائنا، ومن الشجاعة للبحث عن الحلول في الأماكن التي لم نكن لنخطر لنا البحث فيها. البراز الذي نستحي منه قد يصبح، في مستقبل قريب، مفتاحاً لإنقاذ الأرواح.

